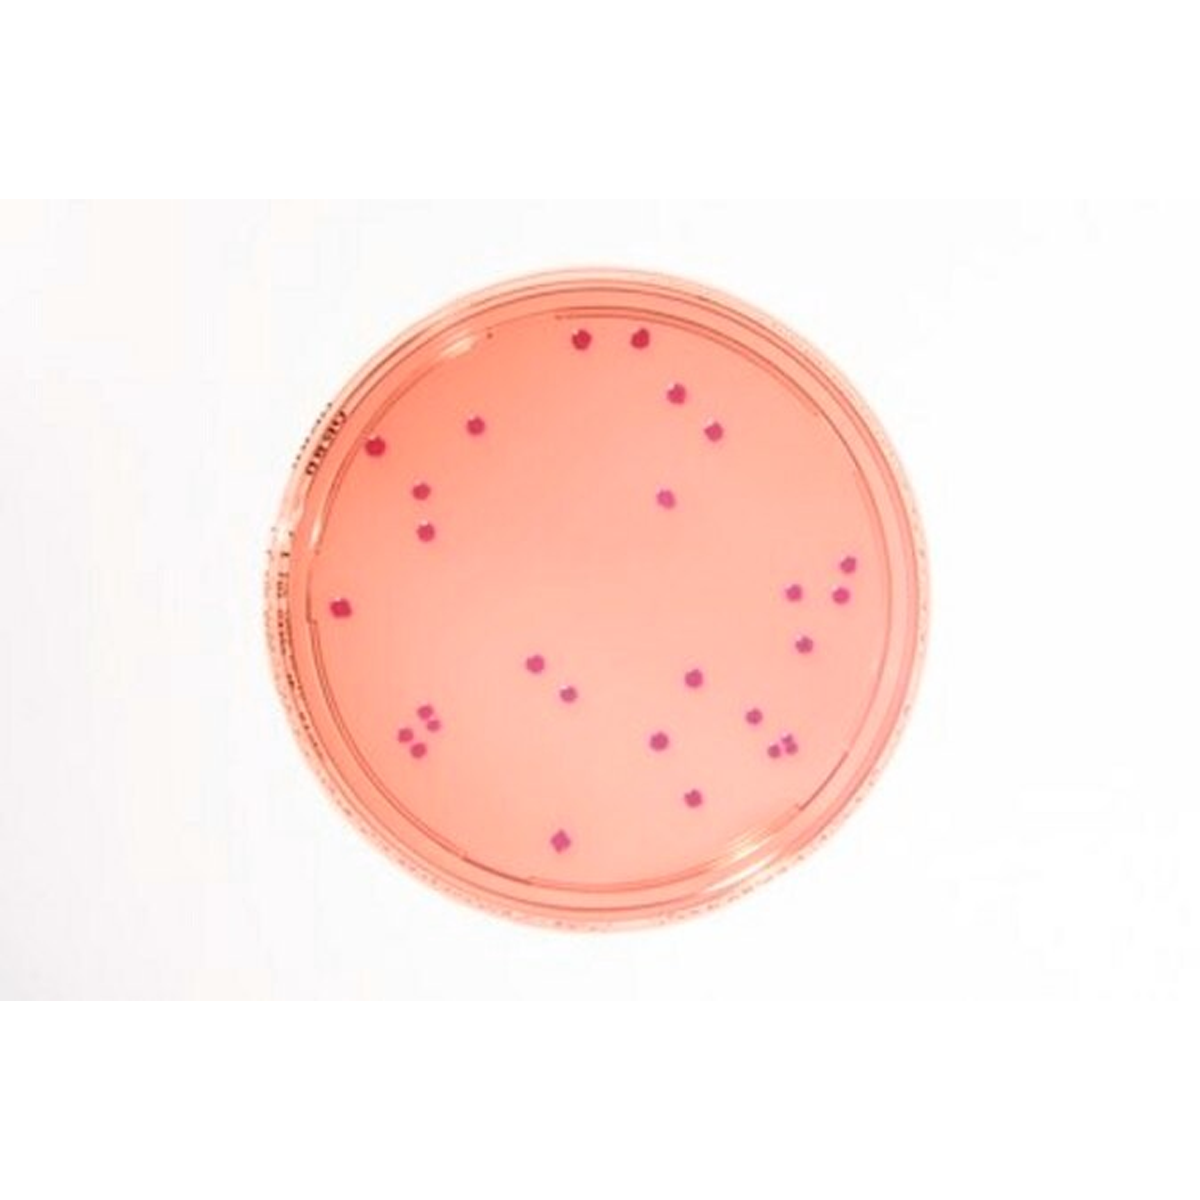

1
/
of
1
SKU:1460000020
Merck
HEIMPLATE Violet Red Bile Dextrose Agar Settle plate
HEIMPLATE Violet Red Bile Dextrose Agar Settle plate
Out of stock
Product description
Product description
Heimplate, APHA, ISO 21528, USP, JP, plate diam. × filling volume 90 mm × 30 mL/ft
Additional information
Additional information